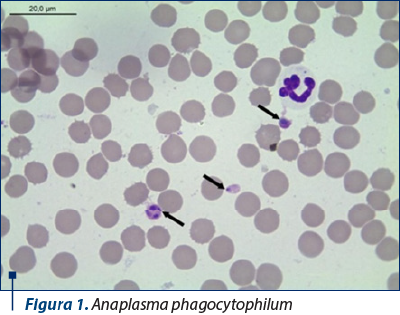
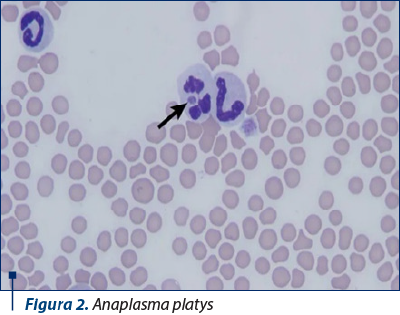

Sindromul hepatorenal în anaplasmoză la canide
Hepatorenal syndrome in anaplasmosis in dogs
Abstract
Canine anaplasmosis is a tick-borne disease caused by two types of Gram-negative and obligate intracellular bacteria of the family Anaplasmataceae: Anaplasma platys and Anaplasma phagocytophilum. Anaplasmosis was diagnosed in eight canids by correlative association of paraclinical data, in the absence of specific symptomatology (general apathy, epileptiform seizures in two individuals – 25%, and anemia in seven canine patients), respectively by means of snap Test 4DX, slide-lamp examination and supported by positivity to the PCR genetic test. Analysis of the biochemical and hematological profile showed monocytosis (6/8), thrombocytopenia (5/8), with impaired renal function, with a mean creatinemia of 2.11 mg/dL, and inconstant liver damage by relative increase in serum transaminases, with a mean of 111 U/I. The basis of renal impairment following anaplasmosis infection is essentially attributed to the occurrence of membranous or proliferative glomerulopathy, which correlates with the data obtained by the increase of the representative renal indicator (serum creatinine) and histopathologic examination results in the investigated cases (n=3).Keywords
anaplasmosishepatorenal syndromedogsRezumat
Anaplasmoza canină este o boală transmisă de căpuşe, provocată de două tipuri de bacterii Gram-negative şi intracelulare obligatorii din familia Anaplasmataceae: Anaplasma platys şi Anaplasma phagocytophilum. Anaplasmoza a fost diagnosticată la opt canide prin asocierea corelativă a datelor paraclinice, în absenţa unei simptomatologii specifice (stare generală de apatie, crize epileptiforme la doi indivizi – 25% şi anemie la şapte pacienţi canini), respectiv prin intermediul snap Test 4DX, examen lamă-lamelă şi susţinut prin pozitivarea la testul genetic PCR. Prin analiza profilului biochimic şi hematologic se constată monocitoză (6/8), trombocitopenie (5/8), cu afectarea funcţionalităţii renale, cu o medie a creatinemiei de 2,11 mg/dL, şi afectare hepatică inconstantă, prin creşterea relativă a transaminazelor serice, cu o medie de 111 U/I. Fundamentul afectării renale în urma infecţiei cu anaplasmoză se atribuie, în esenţă, apariţiei glomerulopatiei de tip membranos sau proliferativ, aspect corelabil cu datele obţinute prin creşterea indicatorului renal reprezentativ (creatinina serică) şi rezultatul examenului histopatologic la cazurile investigate (n=3).Cuvinte Cheie
anaplasmozăsindrom hepatorenalcanideAnaplasmoza canină este o boală transmisă de căpuşe, provocată de două tipuri de bacterii Gram-negative şi intracelulare obligatorii din familia Anaplasmataceae: Anaplasma platys şi Anaplasma phagocytophilum.
Anaplasma phagocytophilum infectează granulocitele şi este responsabilă pentru anaplasmoza granulocitară, o boală care poate afecta şi omul. În Europa, vectorul principal pentru această bacterie este căpuşa Ixodes ricinus.
Anaplasma platys are un tropism pentru trombocite, provocând trombocitopenie ciclică la câini. Vectorul principal pentru A. platys este Rhipicephalus sanguineus.
Rezervoarele naturale pentru aceste bacterii includ rozătoarele, rumegătoarele domestice şi sălbatice şi, posibil, păsările. Seroprevalenţa pentru ambele forme de anaplasmoză variază în diferite regiuni ale Europei, ajungând în unele locuri până la 70%. De multe ori, boala este autolimitantă sau nu prezintă simptome.
Semnele clinice înregistrate sunt letargie, febră, care poate fi ciclică în cazul infecţiei cu Anaplasma platys, inapetenţă, reticenţă la mişcare, şchiopătură, diaree, tulburări hemoragice şi limfadenopatie.
Paraclinic se remarcă trombocitopenie ca factor indicator substanţial, adesea ciclică în cazul infecţiei cu Anaplasma platys, leucopenie, anemie moderată, creşterea uşoară a enzimelor hepatice, hipofosfatemie, hiperproteinemie, hiperglobulinemie şi hipoalbuminemie.
Diagnosticul se stabileşte pe baza datelor anamnetice (câinii care trăiesc în regiuni unde boala este endemică), a semnalmentelor clinice, frotiu sanguin cu identificarea microscopică a agregatelor intracitoplasmatice de bacterii (morulae) în granulocite (pentru A. phagocytophilum) sau în trombocite (pentru A. platys) prin frotiuri de sânge colorate cu Giemsa sau Wright, serologie (ELISA şi IFAT), interpretată în contextul simptomelor clinice şi al istoricului pacientului. O creştere de patru ori a titrului de anticorpi între serul din faza acută şi cel de convalescenţă confirmă diagnosticul, sau prin PCR, care posedă caracter de specificitate şi este indicativ pentru infecţia actuală, fiind decelată la patru-zece zile postinfecţie.
Anaplasmoza a fost diagnosticată la opt canide prin asocierea corelativă a datelor paraclinice, în absenţa unei simptomatologii specifice (stare generală de apatie, crize epileptiforme la doi indivizi – 25% şi anemie la şapte pacienţi canini), respectiv prin intermediul snap Test 4DX, examen lamă-lamelă şi susţinut prin pozitivarea la testul genetic PCR.

În acest studiu, modificările/coafectările funcţionale hepatorenale (aflate la limita superioară) determinate de agentul etiologic Anaplasma phagocytophilum şi Anaplasma platys cu diagnostic stabilit prin intermediul snap Test 4DX, examen lamă-lamelă şi susţinut prin pozitivarea la testul genetic PCR, au fost decelate la opt canide de rasă Metis (n=3), rasa Schnautzer (n=2), rasa Akita (n=2) şi rasa Labrador (n=1), trei de sex feminin (37,5%) şi cinci de sex masculin (62,5%), în grupa de vârstă 1-5 ani fiind încadrate un număr de cinci canide, două animale în grupa 6-10 ani şi un câine la grupa 11-17 ani, fapt susţinut şi de cercetări anterioare care sugerează o prevalenţă crescută pentru sexul masculin (Preyß-Jägeler şi col., 2020).
Datele clinico-anamnestice oferă un fundament absolut vital pentru prezumţia unui diagnostic, permiţând o completare prin intermediul analizelor paraclinice cu biochimie sangvină şi hematologie, fiind remarcate în cadrul examenului clinic o stare generală de apatie la pacienţii afectaţi, crize epileptiforme la doi indivizi (25%), alături de semnul clinic preponderent identificat reprezentat de mucoase anemice la şapte pacienţi canini din cei incluşi în studiul final (87,5%).
Prin analiza profilului biochimic şi hematologic se constată monocitoză (6/8), trombocitopenie (5/8), cu afectarea funcţionalităţii renale, cu o medie a creatinemiei de 2,11 mg/dL, şi afectare hepatică inconstantă prin creşterea relativă a transaminazelor serice cu o medie de 111 U/I.
Fundamentul afectării renale în urma infecţiei cu anaplasmoză se atribuie, în esenţă, apariţiei glomerulopatiei de tip membranos sau proliferativ, aspect corelabil cu datele obţinute prin creşterea indicatorului renal reprezentativ (creatinina serică) şi rezultatul examenului histopatologic la cazurile investigate (n=3).

Analizele biochimice şi hematologice au relevat prezenţa monocitozei şi trombocitopeniei, împreună cu disfuncţii renale, evidenţiate printr-o creştere medie a creatininei de 2,11 mg/dL, şi variabilitate în funcţia hepatică, cu transaminaze serice crescute la o medie de 111 U/L. Aceste semne sunt asociate cu afectarea renală specifică anaplasmozei, care frecvent manifestă glomerulopatii membranoase sau proliferative, aspect confirmat prin rezultatele histopatologice şi nivelurile ridicate ale creatininei serice în cazurile studiate.

Identificarea precoce a anaplasmozei, care poate determina consecinţe hepatorenale, este crucială pentru prevenirea şi gestionarea eficientă a disfuncţiilor hepatorenale, prin limitarea progresiunii procesului morbid şi prevenirea instalării sindromului de insuficienţă hepatică/renală.
Autor corespondent: Mario-Darius Codreanu E-mail: codveterinary@yahoo.com
CONFLICT OF INTEREST: none declared.
FINANCIAL SUPPORT: none declared.
This work is permanently accessible online free of charge and published under the CC-BY.
Bibliografie
-
Bowman D, Little SE, Lorentzen L, Shields J, Sullivan MP, Carlin EP. Prevalence and geographic distribution of Dirofilaria immitis, Borrelia burgdorferi, Ehrlichia canis, and Anaplasma phagocytophilum in dogs in the United States: results of a national clinic-based serologic survey. Vet Parasitol. 2009 Mar 9;160(1-2):138-48. doi: 10.1016/j.vetpar.2008.10.093.
-
Eberts MD, Vissotto de Paiva Diniz PP, Beall MJ, Stillman BA, Chandrashekar R, Breitschwerdt EB. Typical and atypical manifestations of Anaplasma phagocytophilum infection in dogs. J Am Anim Hosp Assoc. 2011 Nov-Dec;47(6):e86-94. doi: 10.5326/JAAHA-MS-5578.
-
El Hamiani Khatat S, Daminet S, Duchateau L, Elhachimi L, Kachani M, Sahibi H. Epidemiological and Clinicopathological Features of Anaplasma phagocytophilum Infection in Dogs: A Systematic Review. Front Vet Sci. 2021 Jun 23;8:686644. doi: 10.3389/fvets.2021.686644.
-
Sirigireddy KR, Ganta RR. Multiplex detection of Ehrlichia and Anaplasma species pathogens in peripheral blood by real-time reverse transcriptase-polymerase chain reaction. J Mol Diagn. 2005 May;7(2):308-16. doi: 10.1016/S1525-1578(10)60559-4.
-
Little SE, Beall MJ, Bowman DD, Chandrashekar R, Stamaris J. Canine infection with Dirofilaria immitis, Borrelia burgdorferi, Anaplasma spp., and Ehrlichia spp. in the United States, 2010-2012. Parasit Vectors. 2014 May 30;7:257. doi: 10.1186/1756-3305-7-257.
-
Savidge C. Granulocytic, Anaplasmosis, Atlantic Veterinary College Charlottetown, Prince Edward Island. 2019.
-
Vázquez-Manzanilla CA, Cárdenas-Marrufo MF, Gutiérrez-Blanco E, Jiménez-Coello M, Pech-Sosa NR, Ortega-Pacheco A. Clinical features of chronic kidney disease in dogs with the serological presence of Leptospira spp., Ehrlichia canis, and Anaplasma phagocytophilum. Animal Diseases. 2023;3:37.




